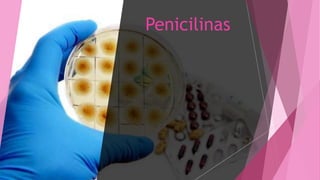
Penicilinas

Este documento describe las características de los fármacos betalactámicos, incluyendo penicilinas, cefalosporinas y sus generaciones. Explica su mecanismo de acción, clasificación, espectro, farmacocinética y usos clínicos. Resume la información sobre las diferentes generaciones de cefalosporinas y sus propiedades.